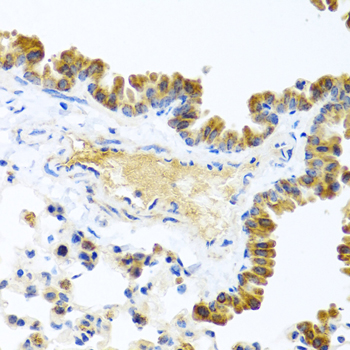
Immunohistochemistry - WNT9A Polyclonal Antibody

-
Product Name
WNT9A Polyclonal Antibody
- Documents
-
Description
Polyclonal antibody to WNT9A
-
Tested applications
WB, IHC, IF
-
Species reactivity
Human, Mouse, Rat
-
Alternative names
WNT9A antibody; WNT14 antibody; protein Wnt-9a antibody
-
Isotype
Rabbit IgG
-
Preparation
Antigen: Recombinant fusion protein containing a sequence corresponding to amino acids 206-365 of human WNT9A (NP_003386.1).
-
Clonality
Polyclonal
-
Formulation
PBS with 0.02% sodium azide, 50% glycerol, pH7.3.
-
Storage instructions
Store at -20℃. Avoid freeze / thaw cycles.
-
Applications
WB 1:500 - 1:2000
IHC 1:100 - 1:200
IF 1:50 - 1:200 -
Validations

Western blot - WNT9A Polyclonal Antibody
Western blot analysis of extracts of mouse lung, using WNT9A antibody at 1:1000 dilution.Secondary antibody: HRP Goat Anti-Rabbit IgG (H+L) at 1:10000 dilution.Lysates/proteins: 25ug per lane.Blocking buffer: 3% nonfat dry milk in TBST.Detection: ECL Basic Kit .Exposure time: 90s.

Immunohistochemistry - WNT9A Polyclonal Antibody
Immunohistochemistry of paraffin-embedded rat lung using WNT9A antibody at dilution of 1:100 (40x lens).

Immunohistochemistry - WNT9A Polyclonal Antibody
Immunohistochemistry of paraffin-embedded human colon using WNT9A antibody at dilution of 1:100 (40x lens).

Immunohistochemistry - WNT9A Polyclonal Antibody
Immunohistochemistry of paraffin-embedded human stomach using WNT9A antibody at dilution of 1:100 (40x lens).
Immunohistochemistry - WNT9A Polyclonal Antibody
Immunohistochemistry of paraffin-embedded mouse lung using WNT9A antibody at dilution of 1:100 (40x lens).

Immunofluorescence - WNT9A Polyclonal Antibody
Immunofluorescence analysis of U2OS cells using WNT9A antibody at dilution of 1:100. Blue: DAPI for nuclear staining.
-
Background
Ligand for members of the frizzled family of seven transmembrane receptors. Functions in the canonical Wnt/beta-catenin signaling pathway. Required for normal timing of IHH expression during embryonic bone development, normal chondrocyte maturation and for normal bone mineralization during embryonic bone development. Plays a redundant role in maintaining joint integrity.
Related Products / Services
Please note: All products are "FOR RESEARCH USE ONLY AND ARE NOT INTENDED FOR DIAGNOSTIC OR THERAPEUTIC USE"
